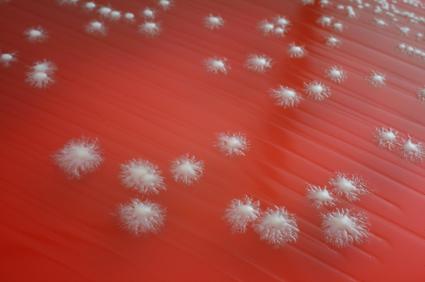
Гъбички

Терорът на гъбичките
Между пръстите, по ноктите, в косата те се множат на влажно и топло
Гъбичките са навсякъде около нас. Носим ги и в тялото си. И ако тези в почвата, в храната и бита не са особено опасни, „роднините“ им, които се заселват в нас, са истински проблем. Няма орган и система, в които да не могат да проникнат, а настанят ли се комфортно, унищожаването им трае месеци.
Защото именно лекарствата, с които най-често ги атакуваме, създават условия за безконтролното им множене. След 10 – 15-дневен антибиотичен курс развъждаме гъбички не само в устата и в храносмилателната система, но и по половите органи и къде ли още не. И месеци след това не можем да се отървем от тях, да възстановим равновесието и да дадем шанс на добрите микроорганизми да вземат надмощие, а имунитетът да се вдигне. Защото голяма част от него се „командва“ от храносмилателния тракт.
Веднъж заселили се в тялото, гъбите търсят топло и влажно. Осигурим ли им условия, се развиват и множат, завземат нови територии. Те невинаги са сигнал за ниска хигиена – напротив.
„Имах пациент – къпеше се по половин час 2 пъти на ден. И колкото повече се мокреше, толкова гъбите „избуяваха“. Сауна, басейн, джакузи имат същия ефект. Прекомерната хигиена и СПА глезотии и уелнес процедури могат да влошат проблема. Докато на село човек може да ходи бос цял ден и да не си мие краката и никога да не хване гъбички“, разказва дерматологът доц. Гриша Матеев от кожната клиника на Александровска болница.
Щом дойде топлият сезон, гъбичките се множат. Най-често се „настаняват“ между пръстите на краката. В Америка дори има определение „атлетично стъпало“, защото е най-разпространено при спортисти, чиито крака са потни и обути в маратонки. Не само спортистите обаче стават тяхна жертва. На прицел са всички, които се налага целогодишно да носят затворени обувки и чорапи. Държавни служители, официални лица през лятото не могат да ходят боси и по сандали. И ако французойката събува чорапогащника още през март, българките често го носят до юли. А „затвореният“ крак не може да диша, стои непрекъснато топъл и влажен, което създава условия за размножаване на заразата. Събуем ли обувките, оставим ли крака сух, няма как да ги завъдим. Ако пък вече сме ги развили, състоянието се облекчава.
„Те не умират от само себе си, трябва лечение, но в много случаи широко рекламираните от телевизионния екран препарати, които се мажат между пръстите и по ходилото, решават проблема за около седмица“, обяснява доц. Матеев.
За разлика от тях гъбите по ноктите са упорити, развиват се целогодишно и искат продължително лечение. И те обичат топло и влажно, но не могат да се излекуват бързо. Само мазането с различни лекарства често е недостатъчно, налага се да се пият, и то продължително. Влагата омекотява нокътната плочка и тя става пропусклива – здравият ѝ щит се пука и вътре се настаняват гъбичките. Те могат да преминат от между пръстите вътре в нокътя.
„Лекарствата, които се рекламират и се мажат върху нокътя, не вършат работа, защото не проникват навътре. Не стигат до корена на нокътя и не лекуват. Трябва да се пият хапчета, обяснява дерматологът. При правилно лечение със специални препарати антибиотикът остава в корена на нокътя и го „пази“ – гъбичките не могат да проникнат. Заразеният участък постепенно израства и ние го изрязваме. Така нокътят остава здрав. Лечението е продължително – понякога до 3 месеца със специфични препарати“, казва доц. Матеев.
Проблемът е, че тези гъбички могат да се „пренесат“ към слабините. Те причиняват зачервяване, подмокряне, парене, сърбеж и подсичане.
Доц. Гриша Матеев, миколог, кожна клиника, Александровска болница: Децата се заразяват от котенца
- Доц. Матеев, за всеки вид гъбичка трябва ли отделно лечение?
- Макар че гъбичките са страшно много видове и е важно да се постави точна диагноза и да се установи видът им, лечението е сведено до 5 – 6 широкоспектърни препарата, за разлика от антибиотиците например.
- Какво е ефективното лечение при гъбички по ноктите?
- То е със специфични препарати, които се пият през устата, и продължава понякога 3 месеца.
- А ваденето на болния нокът?
- Преди години се правеше. Сега не го препоръчваме.
- Децата развиват ли гъбички?
- Децата често имат гъбички по косата, които не са опасни за възрастните.
Те се заразяват едно от друго – в детската ясла и в градината, където контактът е по-близък. Заразата се предава лесно – с общи гребени, шапки. Космите се начупват, окапват, образуват се голи полета.
Другият източник на зараза са котките и кучетата, обикновено когато детето прибере от улицата малко котенце. Но в тези случаи гъбичките са различни.
Те „разяждат“ косата само на малкото дете, не и на възрастните, защото техните косми отделят мастна секреция, която убива гъбичките.
Освен по косата те могат да плъзнат по всички части на тялото. По кожата се явява обрив с формата на кръг с червен ръб, а в центъра е светъл.
На вашето внимание
Състояния и заболявания
Бременност и родителство
- Етикети:
- Рубрики: